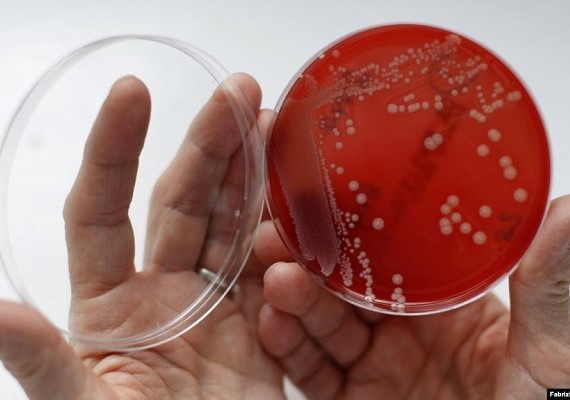

Drug-resistant “superbug” infections have been called a public health threat that could push medical progress back a century. Health experts warn such infections could cause some germs to become untreatable. So there was surprising news in a recent report: superbug deaths in the United States appear to be going down. About 36,000 Americans died from drug-resistant infections in 2017, compared to an estimated 44,000 in 2013. That information comes from the U.S. Centers for Disease Control and Prevention (CDC). The recent CDC report says the decrease is mainly the result of a major effort by hospitals to control the spread of very dangerous infections. “We are pushing back in a battle we were losing,” pharmacist Michael Kirsch told The Associated Press. He works at AdventHealth Tampa, a Florida hospital that has noted lower superbug infection rates.
Title: US Superbug Infections Rising, Deaths Falling
Content: <div id='article-page'><div id='article-content' data-media-url='//news-app-staging.s3.amazonaws.com' data-base-url='//news-app-staging.herokuapp.com' data-sound-name='https://news-app-production.s3.amazonaws.com/articles/3796/bug.wav' data-capture-url='//staging.analytics.lingraphica.com/events/capture_news' data-article-title='US Superbug Infections Rising, Deaths Falling' data-article-id='4340'><script src='//news-app-staging.herokuapp.com/javascripts/getscripts.js'></script><link rel='stylesheet' href='//news-app-staging.herokuapp.com/stylesheets/article.css' type='text/css' /><div class='article'><p><span data-start-time='0' data-end-time='FALSE'>Drug-resistant “superbug” infections have been called a public health threat that could push medical progress back a century.</span> <span data-start-time='10354' data-end-time='18229'>Health experts warn such infections could cause some germs to become untreatable.</span> <span data-start-time='18229' data-end-time='23208'>So there was surprising news in a recent report:</span> <span data-start-time='23208' data-end-time='28917'>superbug deaths in the United States appear to be going down.</span> <span data-start-time='28917' data-end-time='43208'>About 36,000 Americans died from drug-resistant infections in 2017, compared to an estimated 44,000 in 2013.</span> <span data-start-time='43208' data-end-time='52229'>That information comes from the U.S. Centers for Disease Control and Prevention (CDC).</span> <span data-start-time='52229' data-end-time='66583'>The recent CDC report says the decrease is mainly the result of a major effort by hospitals to control the spread of very dangerous infections.</span> <span data-start-time='66583' data-end-time='74917'>“We are pushing back in a battle we were losing,” pharmacist Michael Kirsch told The Associated Press.</span> <span data-start-time='74917' data-end-time='83979'>He works at AdventHealth Tampa, a Florida hospital that has noted lower superbug infection rates.</span> </p></div><div class='control-buttons-sticky' style='display:none;'><div class='control-buttons'><button title='Back' class='back' disabled='disabled'></button><button title='Play' class='play' disabled='disabled'></button><button title='Pause' class='pause' style='display:none;'></button><button title='Forward' class='forward' disabled='disabled'></button><button class='finished-reading' style='display:none;'>Done</button></div></div></div><div id='article-media'><div id='media-image'><img src='https://news-app-production.s3.amazonaws.com/articles/3796/bug.jpg'/></div></div><div id='question-content' style='display:none;'><div class='vocabulary_question question-container' data-question-id=14097 data-hint-location='10354' style='display:none;'><div class='question' data-sound-name='https://news-app-production.s3.amazonaws.com/articles/3796/what_does_germ_mean.wav'>What does germ mean?</div><div class='choices' data-correct-choice='organism that causes disease'><div class='choice' data-sound-name='https://news-app-production.s3.amazonaws.com/articles/3796/resistant_to_infection.wav'><span>resistant to infection</span></div><div class='choice' data-sound-name='https://news-app-production.s3.amazonaws.com/articles/3796/organism_that_causes_disease.wav'><span>organism that causes disease</span></div><div class='choice' data-sound-name='https://news-app-production.s3.amazonaws.com/articles/3796/control_the_spread_.wav'><span>control the spread </span></div><div class='choice' data-sound-name='https://news-app-production.s3.amazonaws.com/articles/3796/lower_infection_rates.wav'><span>lower infection rates</span></div></div></div><div class='multiple_choice_question question-container' data-question-id=14098 data-hint-location='0' style='display:none;'><div class='question' data-sound-name='https://news-app-production.s3.amazonaws.com/articles/3796/what_have_the_infections_been_called.wav'>What have the infections been called?</div><div class='choices' data-correct-choice='a public health threat'><div class='choice' data-sound-name='https://news-app-production.s3.amazonaws.com/articles/3796/a_new_disease_model.wav'><span>a new disease model</span></div><div class='choice' data-sound-name='https://news-app-production.s3.amazonaws.com/articles/3796/very_dangerous_rates.wav'><span>very dangerous rates</span></div><div class='choice' data-sound-name='https://news-app-production.s3.amazonaws.com/articles/3796/compared_to_estimates.wav'><span>compared to estimates</span></div><div class='choice' data-sound-name='https://news-app-production.s3.amazonaws.com/articles/3796/a_public_health_threat.wav'><span>a public health threat</span></div></div></div><div class='sentence_completion_question question-container' data-question-id=14099 data-hint-location='52229' style='display:none;'><div class='question' data-sound-name='https://news-app-production.s3.amazonaws.com/articles/3796/the_decrease_is_the_result_of_efforts_by__blank_.wav'>The decrease is the result of efforts by <span class='blank'>hospitals</span>.</div><div class='choices' data-correct-choice='hospitals'><div class='choice' data-sound-name='https://news-app-production.s3.amazonaws.com/articles/3796/investigators.wav'><span>investigators</span></div><div class='choice' data-sound-name='https://news-app-production.s3.amazonaws.com/articles/3796/pharmacists.wav'><span>pharmacists</span></div><div class='choice' data-sound-name='https://news-app-production.s3.amazonaws.com/articles/3796/hospitals.wav'><span>hospitals</span></div><div class='choice' data-sound-name='https://news-app-production.s3.amazonaws.com/articles/3796/reporters.wav'><span>reporters</span></div></div></div><div class='question-buttons'><button class='skip-button'></button><button class='hint-button'></button><button class='speak-button'></button></div></div></div>
Sound Name: https://news-app-production.s3.amazonaws.com/articles/3796/bug.wav
Preview